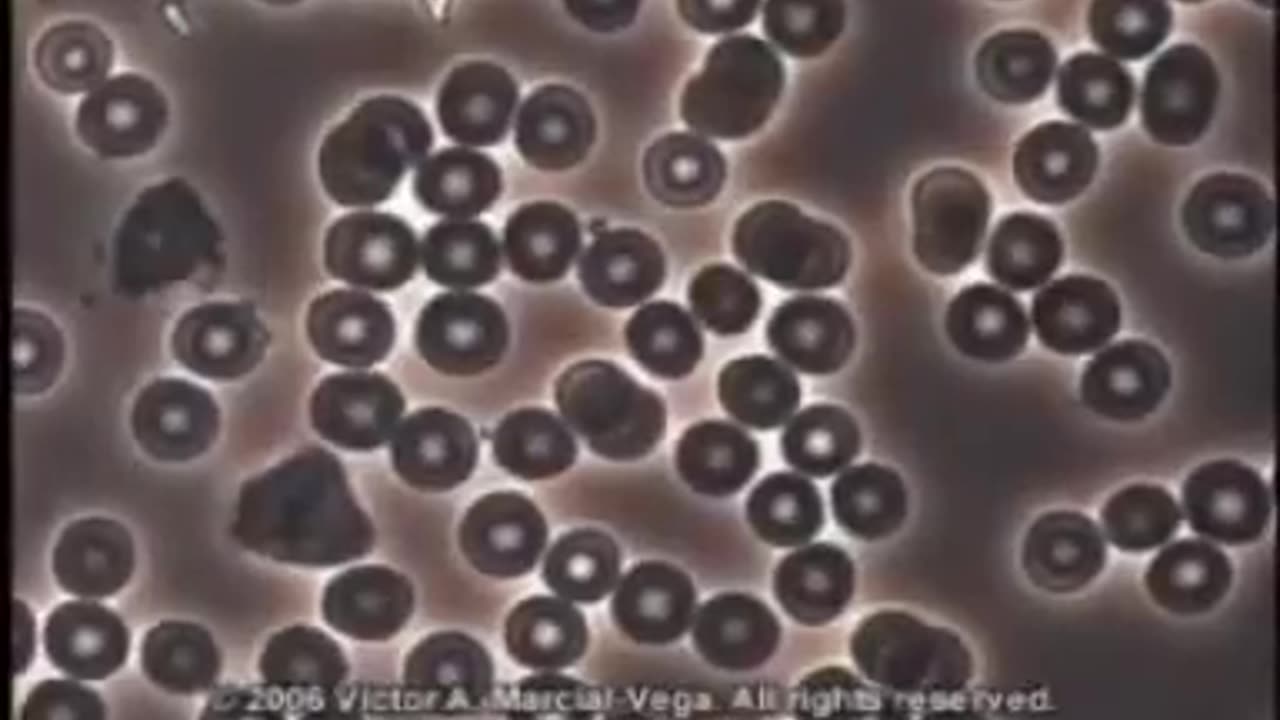

Premium Only Content
This video is only available to Rumble Premium subscribers. Subscribe to
enjoy exclusive content and ad-free viewing.
Alkalinity (1)
Loading comments...
-
LIVE
blackfox87
14 hours ago🟢 SUBATHON DAY 1 | BO7 BETA | Premium Creator | #DisabledVeteran
8,584 watching -
2:24:09
The Quartering
4 hours agoCandace Owens WAR With TPUSA, Antifa BLOWN N OUT, & Pathetic Demand For Trump Interview
106K46 -
3:54:19
Alex Zedra
4 hours agoLIVE! Playing BO7 Beta!
33.2K4 -
1:52:56
TimcastIRL
5 hours agoElon Musk Says Woke NGO Responsible For Charlie Kirk Assassination | Timcast IRL
145K142 -
1:26:12
Steven Crowder
17 hours agoThe Left is Violent (Part 2) | Change My Mind
530K850 -
1:23:53
Man in America
9 hours agoDollar Collapse is Engineered to Herd Us Into CBDC Prison—David Jensen EXPOSES the Playbook
45K13 -
5:16:01
MattMorseTV
9 hours ago $7.99 earned🔴CHILLING + TALKING🔴
94.2K6 -
2:04:23
The Charlie Kirk Show
6 hours agoTHOUGHTCRIME Ep. 99 — THOUGHTCRIME IRL
118K40 -
1:11:34
Flyover Conservatives
13 hours agoSilver Shortage ALERT: London Vaults Running Dry in 4 Months- Dr. Kirk Elliott; 3 Tips to Transform Your Business - Clay Clark | FOC Show
42.5K4 -
1:10:18
Glenn Greenwald
8 hours agoIsrael Pays Influencers $7,000 Per Post in Desperate Propaganda Push: With Journalist Nick Cleveland-Stout; How to "Drink Your Way Sober" With Author Katie Herzog | SYSTEM UPDATE #525
119K133